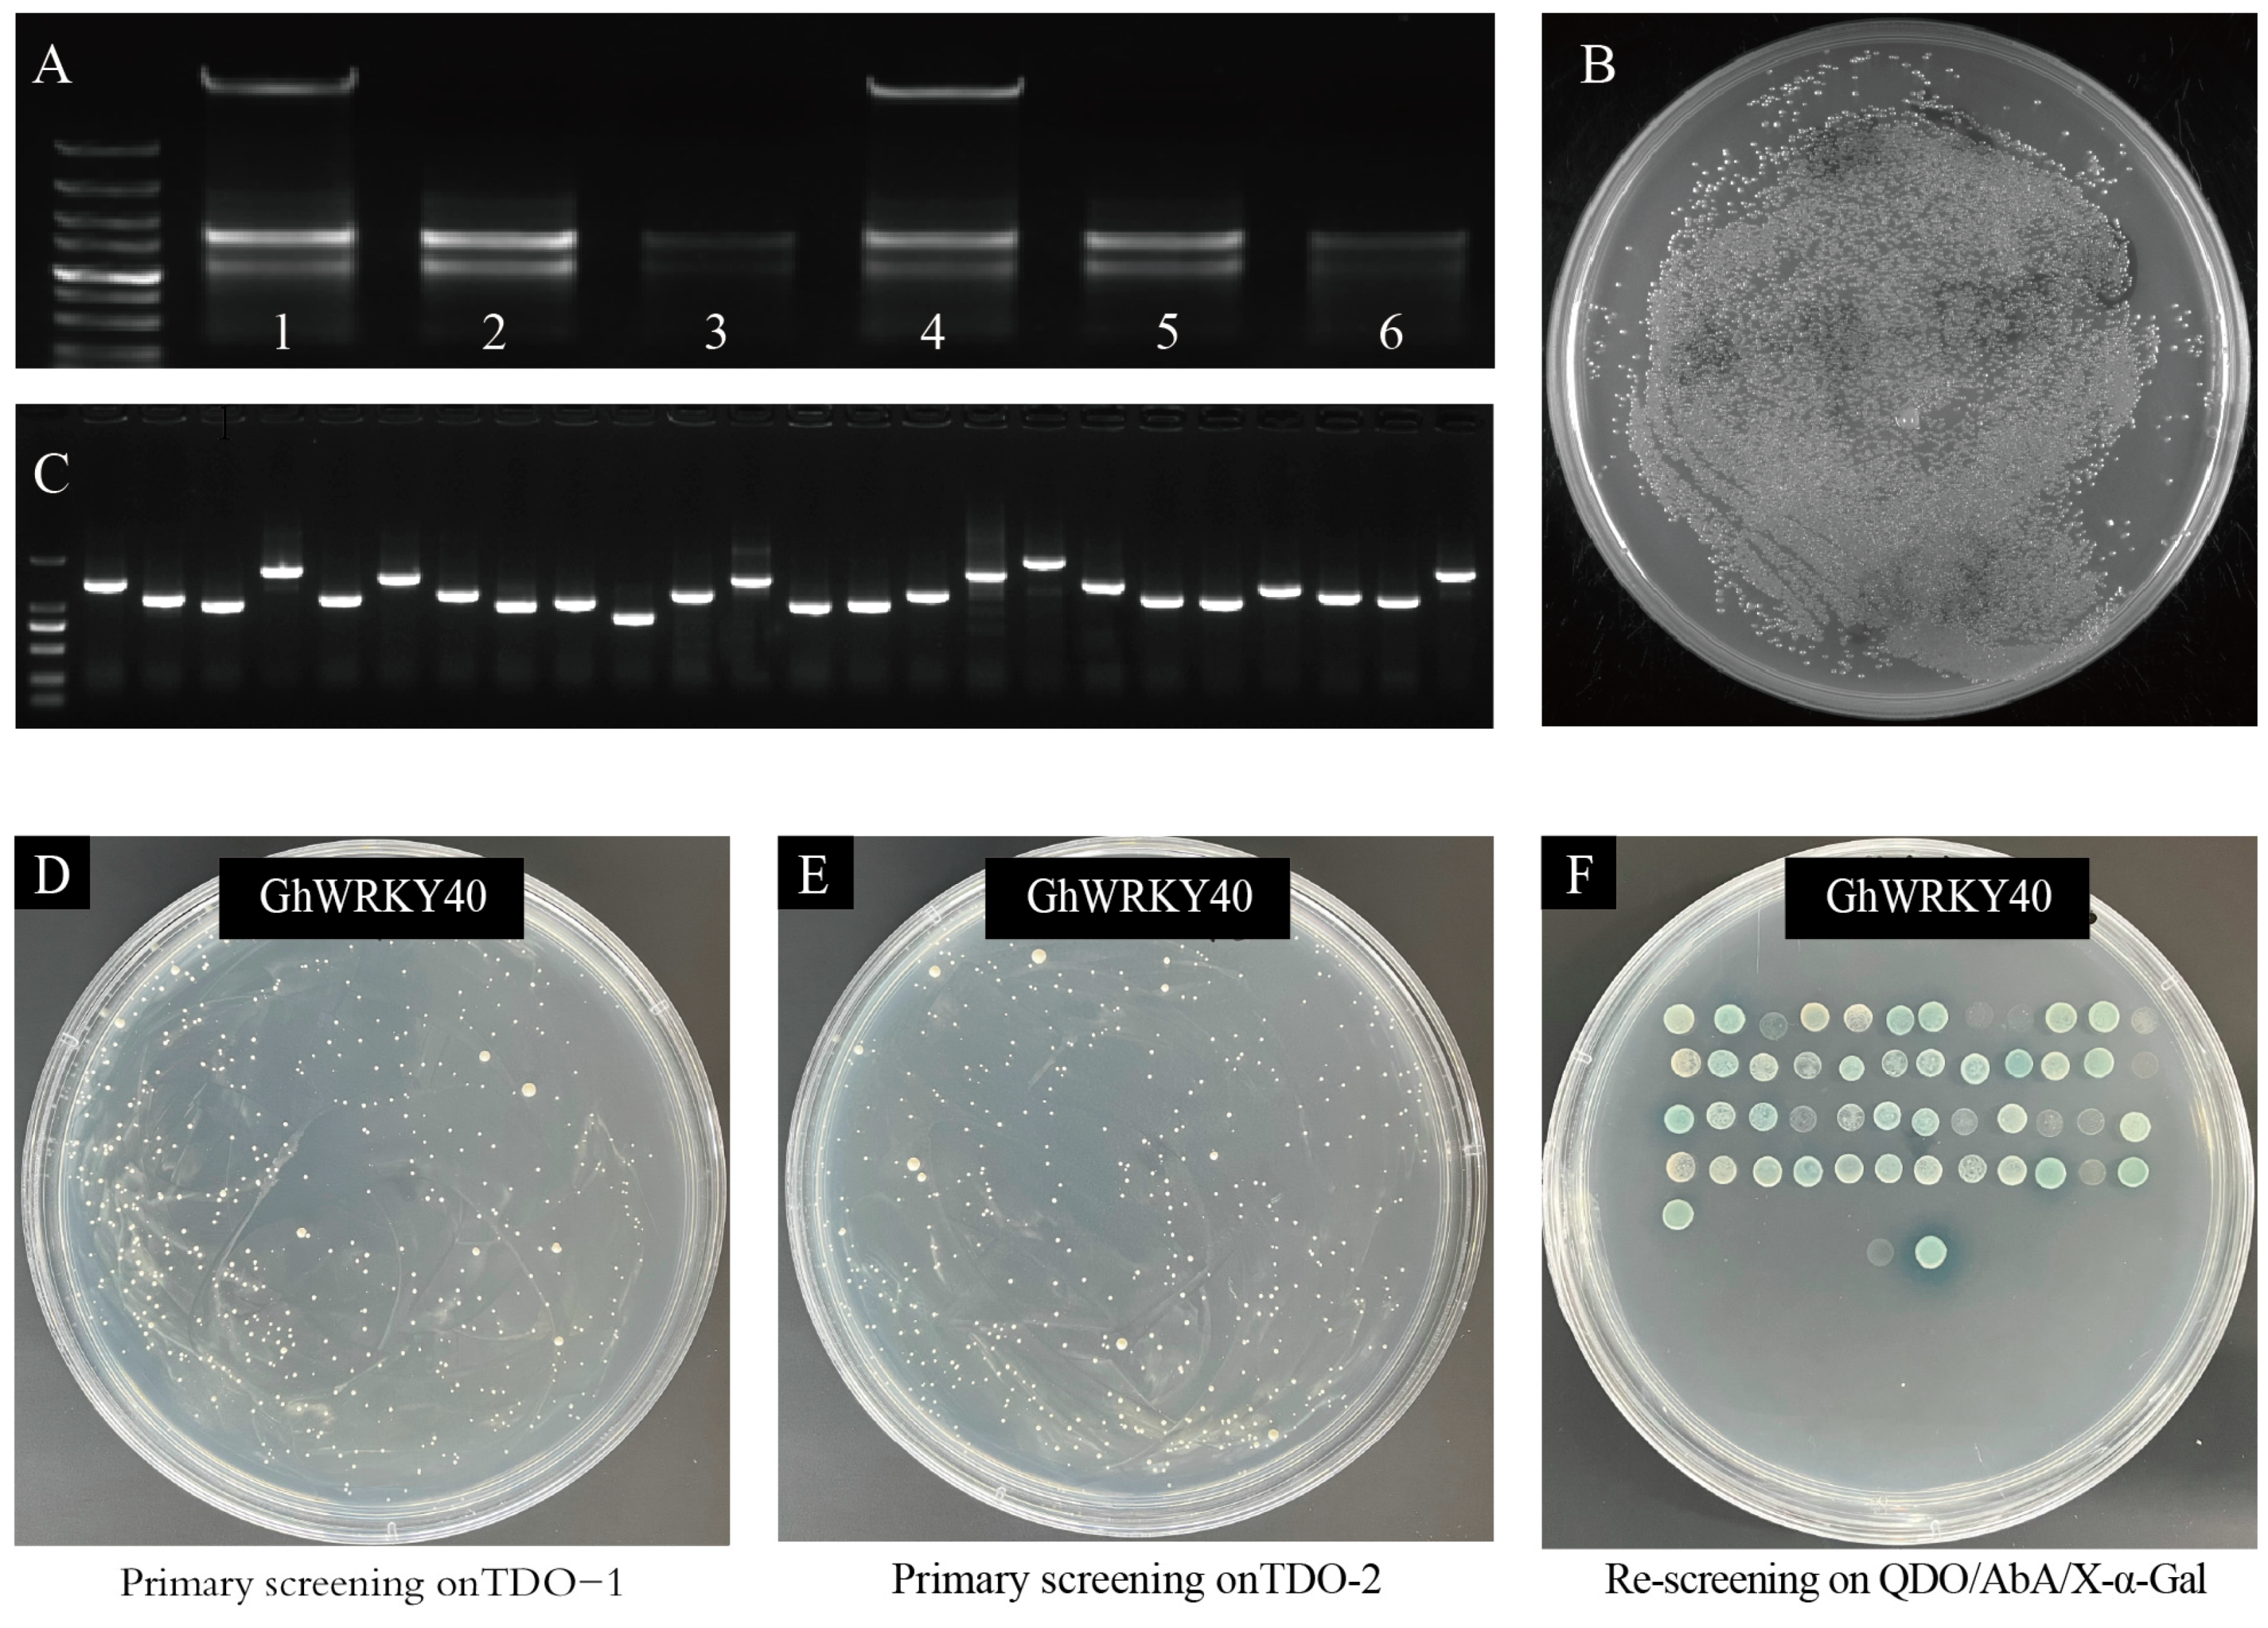

GhWRKY40 Interacts with an Asparaginase GhAPD6 Involved in Fiber Development in Upland Cotton (Gossypium hirsutum L.)
Abstract
1. Introduction
2. Methods and Materials
2.1. Plant Materials
2.2. VIGS Assay
2.3. Scanning and Transmission Electron Microscopic Analysis
2.4. Subcellular Localization
2.5. Construction of Cotton Fiber Nuclear-System Y2H Library
2.6. Screening GhWRKY40-Interacting Proteins Using the Cotton Fiber Y2H Library
2.7. Y2H and Split-Luciferase Complementation Assays
2.8. Verification of Candidate Genes by qRT–PCR
2.9. Aspartyl Protease, Peroxidase, and Indoleacetic Acid Oxidase Activities
3. Results and Discussion
3.1. GhWRKY40 Was Involved in Fiber Strength and Fiber Fineness in the VIGS Assay
3.2. Subcellular Localization of GhWRKY40
3.3. GhWRKY40-Interacting Proteins Were Screened in the Fiber Nuclear-System Y2H Library
3.4. GhWRKY40 Fiber-Related Interactors Were Identified Using Y2H and Split-Luciferase Complementation Assays
3.5. GhWRKY40 May Regulate Fiber Development by Affecting the Activity of Aspartyl Protease
4. Conclusions
Supplementary Materials
Author Contributions
Funding
Institutional Review Board Statement
Informed Consent Statement
Data Availability Statement
Acknowledgments
Conflicts of Interest
References
- Jan, M.; Liu, Z.; Guo, C.; Sun, X. Molecular regulation of cotton fiber development: A review. Int. J. Mol. Sci. 2022, 23, 5004. [Google Scholar] [CrossRef] [PubMed]
- Zou, X.; Liu, A.; Zhang, Z.; Ge, Q.; Fan, S.; Gong, W.; Li, J.; Gong, J.; Shi, Y.; Tian, B.; et al. Co-expression network analysis and hub gene selection for high-quality fiber in upland cotton (Gossypium hirsutum) using RNA sequencing analysis. Genes 2019, 10, 119. [Google Scholar] [CrossRef] [PubMed]
- Si, Z.; Chen, H.; Zhu, X.; Cao, Z.; Zhang, T. Genetic dissection of lint yield and fiber quality traits of G. hirsutum in G. barbadense background. Mol. Breed. 2017, 37, 9. [Google Scholar] [CrossRef]
- Yu, J.; Jung, S.; Cheng, C.; Lee, T.; Zheng, P.; Buble, K.; Crabb, J.; Humann, J.; Hough, H.; Jones, D.; et al. CottonGen: The community database for cotton genomics, genetics, and breeding research. Plants 2021, 10, 2805. [Google Scholar] [CrossRef] [PubMed]
- Fang, L.; Zhao, T.; Hu, Y.; Si, Z.; Zhu, X.; Han, Z.; Liu, G.; Wang, S.; Ju, L.; Guo, M.; et al. Divergent improvement of two cultivated allotetraploid cotton species. Plant Biotechnol. J. 2021, 19, 1325–1336. [Google Scholar] [CrossRef]
- Cao, Z.; Zhu, X.; Chen, H.; Zhang, T. Fine mapping of clustered quantitative trait loci for fiber quality on chromosome 7 using a Gossypium barbadense introgressed line. Mol. Breed. 2015, 35, 215. [Google Scholar] [CrossRef]
- Xu, F.; Chen, Q.; Huang, L.; Luo, M. Advances about the roles of membranes in cotton fiber development. Membranes 2021, 11, 471. [Google Scholar] [CrossRef]
- Fang, L.; Wang, Q.; Hu, Y.; Jia, Y.; Chen, J.; Liu, B.; Zhang, Z.; Guan, X.; Chen, S.; Zhou, B.; et al. Genomic analyses in cotton identify signatures of selection and loci associated with fiber quality and yield traits. Nat. Genet. 2017, 49, 1089–1098. [Google Scholar] [CrossRef] [PubMed]
- Wang, M.; Tu, L.; Lin, M.; Lin, Z.; Wang, P.; Yang, Q.; Ye, Z.; Shen, C.; Li, J.; Zhang, L.; et al. Asymmetric subgenome selection and cis-regulatory divergence during cotton domestication. Nat. Genet. 2017, 49, 579–587. [Google Scholar] [CrossRef]
- Ma, Z.; He, S.; Wang, X.; Sun, J.; Zhang, Y.; Zhang, G.; Wu, L.; Li, Z.; Liu, Z.; Sun, G.; et al. Resequencing a core collection of upland cotton identifies genomic variation and loci influencing fiber quality and yield. Nat. Genet. 2018, 50, 803–813. [Google Scholar] [CrossRef]
- He, S.; Sun, G.; Geng, X.; Gong, W.; Dai, P.; Jia, Y.; Shi, W.; Pan, Z.; Wang, J.; Wang, L.; et al. The genomic basis of geographic differentiation and fiber improvement in cultivated cotton. Nat. Genet. 2021, 53, 916–924. [Google Scholar] [CrossRef] [PubMed]
- Wang, M.; Qi, Z.; Thyssen, G.; Naoumkina, M.; Jenkins, J.; McCarty, J.; Xiao, Y.; Li, J.; Zhang, X.; Fang, D. Genomic interrogation of a MAGIC population highlights genetic factors controlling fiber quality traits in cotton. Commun. Biol. 2022, 5, 60. [Google Scholar] [CrossRef] [PubMed]
- Wang, N.; Ma, Q.; Wu, M.; Pei, W.; Song, J.; Jia, B.; Liu, G.; Sun, H.; Zang, X.; Yu, S.; et al. Genetic variation in MYB5_A12 is associated with fibre initiation and elongation in tetraploid cotton. Plant Biotechnol. J. 2021, 19, 1892–1894. [Google Scholar] [CrossRef]
- Ye, L.; Chen, Y.; Chen, K.; Yang, D.; Ding, L.; Yang, Q.; Xu, C.; Chen, J.; Zhang, T.; Hu, Y. Cotton genes GhMML1 and GhMML2 control trichome branching when ectopically expressed in tobacco. Gene 2022, 820, 146308. [Google Scholar] [CrossRef] [PubMed]
- Gao, Z.; Sun, W.; Wang, J.; Zhao, C.; Zuo, K. GhbHLH18 negatively regulates fiber strength and length by enhancing lignin biosynthesis in cotton fibers. Plant Sci. 2019, 286, 7–16. [Google Scholar] [CrossRef] [PubMed]
- Li, W.; Li, D.; Han, L.; Tao, M.; Hu, Q.; Wu, W.; Zhang, J.; Li, X.; Huang, G. Genome-wide identification and characterization of TCP transcription factor genes in Upland cotton (Gossypium hirsutum). Sci. Rep. 2017, 7, 10118. [Google Scholar] [CrossRef] [PubMed]
- Wen, X.; Chen, Z.; Yang, Z.; Wang, M.; Jin, S.; Wang, G.; Zhang, L.; Wang, L.; Li, J.; Saeed, S.; et al. A comprehensive overview of cotton genomics, biotechnology and molecular biological studies. Sci. China Life Sci. 2023, 66, 2214–2256. [Google Scholar] [CrossRef] [PubMed]
- Finatto, T.; Viana, V.; Woyann, L.; Busanello, C.; Maia, L.; Oliveira, A. Can WRKY transcription factors help plants to overcome environmental challenges? Genet. Mol. Biol. 2018, 41, 533–544. [Google Scholar] [CrossRef] [PubMed]
- Song, H.; Cao, Y.; Zhao, L.; Zhang, J.; Li, S. Review: WRKY transcription factors: Understanding the functional divergence. Plant Sci. 2023, 334, 111770. [Google Scholar] [CrossRef]
- Wang, N.; Li, Y.; Chen, Y.; Lu, R.; Zhou, L.; Wang, Y.; Zheng, Y.; Li, X. Phosphorylation of WRKY16 by MPK3-1 is essential for its transcriptional activity during fiber initiation and elongation in cotton (Gossypium hirsutum). Plant Cell 2021, 10, 1235. [Google Scholar] [CrossRef]
- Yang, D.; Liu, Y.; Cheng, H.; Wang, Q.; Lv, L.; Zhang, Y.; Song, G.; Zuo, D. Identification of the group III WRKY subfamily and the functional analysis of GhWRKY53 in Gossypium hirsutum L. Plants 2021, 10, 1235. [Google Scholar] [CrossRef] [PubMed]
- Ni, Z.; Jiadela, T.; Qiu, Y.; Qu, Y.; Chen, Q. Cloning and characterization of the GbWRKY40 transcription factor gene from Gossypium barbadense L. Cotton Sci. 2017, 29, 393–400. [Google Scholar] [CrossRef]
- Zhang, S.; Wang, H.; Li, X.; Tang, L.; Cai, X.; Liu, C.; Zhang, X.; Zhang, J. Aspartyl proteases identified as candidate genes of a fiber length QTL, qFLD05, that regulates fiber length in cotton (Gossypium hirsutum L.). Theor. Appl. Genet. 2024, 137, 59. [Google Scholar] [CrossRef] [PubMed]
- Huang, H.; Wang, Y.; Li, L.; Lu, H.; Lu, J.; Wang, X.; Ye, Z.; Zhang, Z.; He, Y.; Lu, G.; et al. Planthopper salivary sheath protein LsSP1 contributes to manipulation of rice plant defenses. Nat. Commun. 2023, 14, 737. [Google Scholar] [CrossRef] [PubMed]
- Zhang, Z.; Zhou, Y.; Li, Y.; Shao, S.Q.; Li, B.Y.; Shi, H.Y.; Li, X.B. Interactome analysis of the six cotton 14-3-3s that are preferentially expressed in fibres and involved in cell elongation. J. Exp. Bot. 2010, 61, 3331–3344. [Google Scholar] [CrossRef] [PubMed]
- Zang, Y.; Hu, Y.; Xu, C.; Wu, S.; Wang, Y.; Ning, Z.; Han, Z.; Si, Z.; Shen, W.; Zhang, Y.; et al. GhUBX controlling helical growth results in production of stronger cotton fiber. iScience 2021, 24, 102930. [Google Scholar] [CrossRef] [PubMed]
- Zhang, R.; Shen, C.; Zhu, D.; Le, Y.; Wang, N.; Li, Y.; Zhang, X.; Lin, Z. Fine-mapping and candidate gene analysis of qFL-c10-1 controlling fiber length in upland cotton (Gossypium hirsutum L.). Theor. Appl. Genet. 2022, 135, 4483–4494. [Google Scholar] [CrossRef] [PubMed]
- Lu, L.; Wei, W.; Li, Q.T.; Bian, X.H.; Lu, X.; Hu, Y.; Cheng, T.; Wang, Z.Y.; Jin, M.; Tao, J.J.; et al. A transcriptional regulatory module controls lipid accumulation in soybean. New Phytol. 2021, 231, 661–678. [Google Scholar] [CrossRef] [PubMed]
- Zumba, J.; Rodgers, J. Cotton micronaire measurements using small portable near-infrared (NIR) analyzers. Appl. Spectrosc. 2016, 70, 794–803. [Google Scholar] [CrossRef]
- Huang, G.Q.; Gong, S.Y.; Xu, W.L.; Li, W.; Li, P.; Zhang, C.J.; Li, D.D.; Zheng, Y.; Li, F.G.; Li, X.B. A fasciclin-like arabinogalactan protein, GhFLA1, is involved in fiber initiation and elongation of cotton. Plant Physiol. 2013, 161, 1278–1290. [Google Scholar] [CrossRef]
- Ashraf, F.; Khan, A.A.; Iqbal, N.; Mahmood, Z.; Ghaffar, A.; Khan, Z. In silico analysis and expression profiling of Expansin A4, BURP domain protein RD22-like and E6-like genes associated with fiber quality in cotton. Mol. Biol. Rep. 2022, 49, 5521–5534. [Google Scholar] [CrossRef] [PubMed]
- Wang, Q.; Lei, S.; Yan, J.; Song, Y.; Qian, J.; Zheng, M.; Hsu, Y.F. UBC6, a ubiquitin-conjugating enzyme, participates in secondary cell wall thickening in the inflorescence stem of Arabidopsis. Plant Physiol. Biochem. 2023, 205, 108152. [Google Scholar] [CrossRef]
- Li, D.D.; Ruan, X.M.; Zhang, J.; Wu, Y.J.; Wang, X.L.; Li, X.B. Cotton plasma membrane intrinsic protein 2s (PIP2s) selectively interact to regulate their water channel activities and are required for fibre development. New Phytol. 2013, 199, 695–707. [Google Scholar] [CrossRef] [PubMed]
- Gul, A.; Hussain, G.; Iqbal, A.; Rao, A.Q.; Din, S.U.; Yasmeen, A.; Shahid, N.; Ahad, A.; Latif, A.; Azam, S.; et al. Constitutive expression of Asparaginase in Gossypium hirsutum triggers insecticidal activity against Bemisia tabaci. Sci. Rep. 2020, 10, 8958. [Google Scholar] [CrossRef] [PubMed]
- He, P.; Xiao, G.; Liu, H.; Zhang, L.; Zhao, L.; Tang, M.; Huang, S.; An, Y.; Yu, J. Two pivotal RNA editing sites in the mitochondrial atp1mRNA are required for ATP synthase to produce sufficient ATP for cotton fiber cell elongation. New Phytol. 2018, 218, 167–182. [Google Scholar] [CrossRef]
- Cao, S.; Guo, M.; Cheng, J.; Cheng, H.; Liu, X.; Ji, H.; Liu, G.; Cheng, Y.; Yang, C. Aspartic proteases modulate programmed cell death and secondary cell wall synthesis during wood formation in poplar. J. Exp. Bot. 2022, 73, 6876–6890. [Google Scholar] [CrossRef]
- Sebastián, D.; Fernando, F.; Raúl, D.; Gabriela, G. Overexpression of Arabidopsis aspartic protease APA1 gene confers drought tolerance. Plant Sci. 2020, 292, 110406. [Google Scholar] [CrossRef]
- Wang, B. Study on the Mechanism of Secondary Xylem Development Regulated by Aspartic Protease (PtoAED3) of Populus tomentosa. Ph.D. Dissertation, Beijing Forestry University, Beijing, China, 2024. (In Chinese). [Google Scholar]
- Zhang, W.J.; Hu, H.B.; Wang, Y.H.; Chen, B.L.; Shu, H.M.; Zhou, Z.G. Fiber strength and enzyme activities of different cotton genotypes during fiber development. Sci. Agric. Sin. 2007, 40, 2177–2184. (In Chinese) [Google Scholar]
- Arpat, A.B.; Waugh, M.; Sullivan, J.P.; Gonzales, M.; Frisch, D.; Main, D.; Wood, T.; Lesliel, A.; Wing, R.A.; Wilkins, T.A. Functional genomics of cell elongation in developing cotton fibers. Plant Mol. Biol. 2004, 54, 911–929. [Google Scholar] [CrossRef]

| Number of Environments | Trait | A1 | A29 | ||
|---|---|---|---|---|---|
| Mean | SD | Mean | SD | ||
| 5 | Fiber strength (mm) | 33.00 | 0.80 | 28.61 | 0.79 |
| Fiber length (mm) | 31.49 | 0.69 | 28.88 | 0.73 | |
| No. of Spots | Protein Prediction | Blasted ID on NCBI |
|---|---|---|
| 1 | PREDICTED: GC2:C35 um glucose-6-phosphate isomerase 1, chloroplastic-like (LOC108489870), mRNA | Sequence ID: XM_017794574.2Length: 2420 |
| 2 | PREDICTED: G. hirsutum RPM1-interacting protein 4 (LOC107961948), transcript variant X2, mRNA | Sequence ID: XM_041115985.1Length: 928 |
| 3 | PREDICTED: Gossypium arboreum probable protein phosphatase 2C 33 (LOC108460622), transcript variant X2, mRNA | Sequence ID: XM_017760185.2Length: 2627 |
| 4 | PREDICTED: G. hirsutum external alternative NAD(P)H-ubiquinone oxidoreductase B2, mitochondrial (LOC107900620), mRNA | Sequence ID: XM_016826287.2Length: 2190 |
| 5 | PREDICTED: G. hirsutum BURP domain protein RD22 (LOC107958896), transcript variant X2, mRNA | Sequence ID: XM_041112951.1Length: 1357 |
| 6 | PREDICTED: G. hirsutum pre-mRNA-splicing factor SPF27 homolog (LOC107902058), transcript variant X4, mRNA | Sequence ID: XM_016828321.2Length: 1136 |
| 7 | PREDICTED: G. hirsutum pyruvate kinase, cytosolic isozyme (LOC107908997), mRNA | Sequence ID: XM_016836346.2Length: 1903 |
| 10 | PREDICTED: G. hirsutum transcription repressor MYB6-like (LOC121210905), mRNA | Sequence ID:XM_041082841.1Length: 1236 |
| 11 | PREDICTED: G. hirsutum 60S ribosomal protein L5 (LOC107954724), mRNA | Sequence ID: XM_016890373.2Length: 1293 |
| 13 | PREDICTED: G. hirsutum nucleoside diphosphate kinase 2, chloroplastic (LOC107931375), mRNA | Sequence ID: XM_016863254.2Length: 959 |
| 14 | PREDICTED: G. hirsutum elongation factor 1-α-like (LOC121230455), mRNA | Sequence ID: XM_041115288.1Length: 1680 |
| 15 | PREDICTED: G. arboreum dnaJ protein homolog 1-like (LOC108459579), mRNA | Sequence ID: XM_017758969.2Length: 1702 |
| 16 | PREDICTED: G. hirsutum 26S proteasome regulatory subunit 7A (LOC107906028), mRNA | Sequence ID: XM_016832870.2Length: 1554 |
| 17 | PREDICTED: G. hirsutum uridine 5’-monophosphate synthase (LOC107903544), mRNA | Sequence ID: XM_016829617.2Length: 1816 |
| 18 | G. hirsutum fasciclin-like arabinogalactan protein 12 (LOC107889256), mRNA | Sequence ID: NM_001326759.2Length: 1177 |
| 19 | PREDICTED: G. hirsutum glyceraldehyde-3-phosphate dehydrogenase 2, cytosolic (LOC107899696), mRNA | Sequence ID: XM_016825467.2Length: 1560 |
| 20 | PREDICTED: G. hirsutum cysteine synthase (LOC107893759), transcript variant X3, mRNA | Sequence ID: XM_041086207.1Length: 1350 |
| 21 | PREDICTED: G. hirsutum bromodomain-containing protein 9-like (LOC107905723), transcript variant X2, mRNA | Sequence ID: XM_041094008.1Length: 2513 |
| 22 | PREDICTED: G. hirsutum ubiquitin-conjugating enzyme E2 2 (LOC121209837), mRNA | Sequence ID: XM_041081548.1Length: 1129 |
| 23 | G. hirsutum ATP synthase subunit delta’, mitochondrial-like (LOC107950798), mRNA; nuclear gene for mitochondrial product | Sequence ID: NM_001327581.2Length: 884 |
| 25 | PREDICTED: G. arboreum probable aquaporin PIP2-8 (LOC108482897), mRNA | Sequence ID: XM_017785996.2Length: 1064 |
| 26 | PREDICTED: G. hirsutum uncharacterized LOC107889703 (LOC107889703), transcript variant X2, mRNA | Sequence ID: XM_016814230.2Length: 1212 |
| 27 | PREDICTED: G. hirsutum trafficking protein particle complex subunit 6B (LOC107961859), mRNA | Sequence ID: XM_016898021.2Length: 952 |
| 28 | PREDICTED: G. arboreum SUMO-conjugating enzyme SCE1 (LOC108474073), mRNA | Sequence ID: XM_017775966.2Length: 932 |
| 29 | PREDICTED: G. arboreum glyceraldehyde-3-phosphate dehydrogenase 2, cytosolic-like (LOC108456798), mRNA | Sequence ID: XM_017755477.2Length: 1619 |
| 30 | PREDICTED: G. hirsutum elongation factor 1-α (LOC107922028), mRNA | Sequence ID: XM_016851852.2Length: 1697 |
| 31 | PREDICTED: G. hirsutum uncharacterized LOC107899290 (LOC107899290), mRNA | Sequence ID: XM_016824958.2Length: 1353 |
| 32 | PREDICTED: G. hirsutum uncharacterized LOC107925865 (LOC107925865), transcript variant X3, mRNA | Sequence ID: XM_016856595.2Length: 3458 |
| 33 | PREDICTED: G. hirsutum bifunctional 3-dehydroquinate dehydratase/shikimate dehydrogenase, chloroplastic (LOC107888918), mRNA | Sequence ID: XM_016813187.2Length: 1970 |
| 36 | PREDICTED: Gossypium raimondii proteasome subunit β type-1 (LOC105790336), mRNA | Sequence ID: XM_012617892.2Length: 1007 |
| 37 | PREDICTED: G. arboreum V-type proton ATPase subunit E (LOC108450890), mRNA | Sequence ID: XM_017748687.2Length: 1291 |
| 38 | PREDICTED: G. hirsutum eukaryotic translation initiation factor 3 subunit G (LOC107943593), transcript variant X1, mRNA | Sequence ID: XM_016877363.2Length: 1196 |
| 39 | PREDICTED: G. hirsutum FKBP12-interacting protein of 37 kDa (LOC107926722), mRNA | Sequence ID: XM_016857634.2Length: 1477 |
| 40 | PREDICTED: G. hirsutum nardilysin-like (LOC107954265), transcript variant X3, mRNA | Sequence ID: XM_041096636.1Length: 1232 |
| 41 | PREDICTED: G. hirsutum protein EMBRYO DEFECTIVE 514 (LOC107912133), mRNA | Sequence ID: XM_016840199.2Length: 1086 |
| 42 | PREDICTED: G. hirsutum S-adenosylmethionine synthase 1 (LOC107911137), mRNA | Sequence ID: XM_016839024.2Length: 1647 |
| 43 | PREDICTED: G. hirsutum patellin-3 (LOC107904905), mRNA | Sequence ID: XM_016831418.2Length: 2448 |
| 44 | PREDICTED: G. hirsutum lipoyl synthase, mitochondrial (LOC107920229), mRNA | Sequence ID: XM_016849822.2Length: 1613 |
| 45 | PREDICTED: G. hirsutum probable isoaspartyl peptidase/L-asparaginase 2 (LOC107930584), mRNA | Sequence ID: XM_016862250.2Length: 1373 |
| 46 | PREDICTED: G. hirsutum ATP synthase subunit O, mitochondrial (LOC107945533), mRNA | Sequence ID: XM_016879586.2Length: 1104 |
| 48 | PREDICTED: G. hirsutum heat shock cognate protein 80-like (LOC107926182), mRNA | Sequence ID: XM_016856976.2Length: 2511 |
| 49 | PREDICTED: G. hirsutum translocase of chloroplast 159, chloroplastic-like (LOC107933293), mRNA | Sequence ID: XM_016865463.2Length: 4119 |
Disclaimer/Publisher’s Note: The statements, opinions and data contained in all publications are solely those of the individual author(s) and contributor(s) and not of MDPI and/or the editor(s). MDPI and/or the editor(s) disclaim responsibility for any injury to people or property resulting from any ideas, methods, instructions or products referred to in the content. |
© 2024 by the authors. Licensee MDPI, Basel, Switzerland. This article is an open access article distributed under the terms and conditions of the Creative Commons Attribution (CC BY) license (https://creativecommons.org/licenses/by/4.0/).
Share and Cite
Zhang, S.; Cai, X.; Wei, J.; Wang, H.; Liu, C.; Li, X.; Tang, L.; Zhou, X.; Zhang, J. GhWRKY40 Interacts with an Asparaginase GhAPD6 Involved in Fiber Development in Upland Cotton (Gossypium hirsutum L.). Genes 2024, 15, 979. https://doi.org/10.3390/genes15080979
Zhang S, Cai X, Wei J, Wang H, Liu C, Li X, Tang L, Zhou X, Zhang J. GhWRKY40 Interacts with an Asparaginase GhAPD6 Involved in Fiber Development in Upland Cotton (Gossypium hirsutum L.). Genes. 2024; 15(8):979. https://doi.org/10.3390/genes15080979
Chicago/Turabian StyleZhang, Sujun, Xiao Cai, Jingyan Wei, Haitao Wang, Cunjing Liu, Xinghe Li, Liyuan Tang, Xiaodong Zhou, and Jianhong Zhang. 2024. "GhWRKY40 Interacts with an Asparaginase GhAPD6 Involved in Fiber Development in Upland Cotton (Gossypium hirsutum L.)" Genes 15, no. 8: 979. https://doi.org/10.3390/genes15080979
APA StyleZhang, S., Cai, X., Wei, J., Wang, H., Liu, C., Li, X., Tang, L., Zhou, X., & Zhang, J. (2024). GhWRKY40 Interacts with an Asparaginase GhAPD6 Involved in Fiber Development in Upland Cotton (Gossypium hirsutum L.). Genes, 15(8), 979. https://doi.org/10.3390/genes15080979







